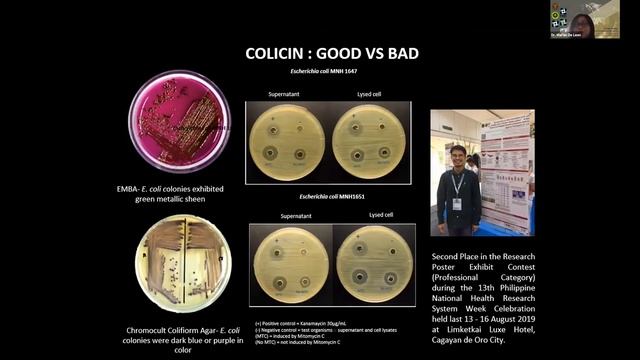
CAVES Launch Mini-Talks: Cave Microbes by Dr. Marian P. De Leon смотреть онлайн

Автор / Канал: Лесная фантазия Страница 2

Eureka Subsea Cable Project - The HDD Company
CAVES Launch Mini-Talks: Cave Microbes by Dr. Marian P. De Leon

ОПОРЫ ЛЭП НА ПРИРОДЕ! 😉

Балансировка сцепления 02E

How to Draw Mushroom Very Easy Drawing for Kids Digital Art

Stuffed Portobello Mushrooms Recipe

BIOTEKNOLOGI MEMBUAT TEMPE SMAN 1 INDRALAYA SELATAN

Копы любят нас 😎😎😎😎😎😎😎😎😎😎😎 песня !!!!!!!!!!!!!!!!!!!!!!

4.3 Пересечение отрезков. Вложенные и каскадные условия. "Поколение Python": курс для начинающих.

DIY How to Make Flavored Vinegar With Kombucha & Juice (Make it TASTE good!)

Beach House, "Burrata Cheese with Truffle Caviar"

ЧТО ТО Я ТАКАЯ СЧАСТЛИВАЯ - ХОРОШИЕ ЛЮДИ ВОШЛИ В МОЙ ДЕНЬ - ОПЯТЬ НАЧИНАЮ НОВУЮ ЖИЗНЬ

Dove Volano I Corvi D'argento - Где Летают Серебристые Вороны

САҢЫРАУҚҰЛАҚ ЖҮРЕДІ ЕКЕН ҚЫЗЫҚТЫ ДЕРЕК

Подъем с глубины

1 Ульяновка

Видео про огурцы

КФХ Гизатуллин

Массажный пояс для похудения

Все умею - Все могу 2.6 l Колхозный выхлоп на Машину за 1$ СВОИМИ РУКАМИ

Грибы Тает лед (пародия)

Музыка-копы (Грибы)

Snow mushroom benefits for your skin # skincare #skincaretips #antiaging

Curso Ovos de Páscoa Gourmet Online
За каждым успешным каналом стоит личность, идея и сотни часов кропотливого труда. Если вы здесь, значит, автор «Лесная фантазия» уже сумел зацепить ваше внимание своим уникальным стилем или подачей. А мы на RUVIDEO позаботились о том, чтобы вы могли изучить весь архив его работ в максимально комфортных условиях — без лишней суеты и преград.
Почему за работами канала «Лесная фантазия» так интересно наблюдать? Всё просто: это честный контент, который находит отклик в сердцах зрителей. На нашем ресурсе вы можете смотреть онлайн все видео любимого автора бесплатно и в хорошем качестве. Нам важно, чтобы вы видели каждую деталь и слышали каждый нюанс, поэтому мы используем только стабильные плееры из открытых источников Rutube.
Следите за новинками канала, пересматривайте старые шедевры и открывайте для себя новые грани творчества «Лесная фантазия». Мы постоянно обновляем ленту, чтобы у вас под рукой всегда были самые свежие выпуски. Никаких сложных регистраций — только вы и творчество, которое вдохновляет. Приятного вам путешествия по миру авторского контента на RUVIDEO!
Видео взято из открытых источников Rutube. Если вы правообладатель, обратитесь к первоисточнику.